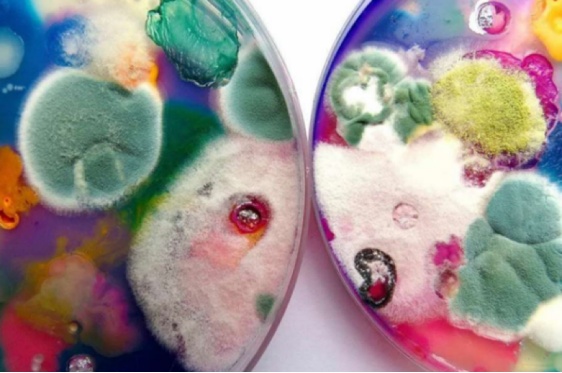

编辑:四月
有一天
同事神神秘秘的问小编
知道这是啥不?

我说:
好像一块变异的口香糖
同事说:
嘿嘿,它是一个宠物
......
电脑前的你是否
和小编一样有很多问号

没错
它就是当下很流行的宠物
黏 菌

尽管名字带个菌
但黏菌不是菌
黏菌既不是真菌也不是细菌,而是一种真核生物域-变形虫总群-黏菌纲的生物,无毒无害。它的一生有两个阶段:营养阶段和繁殖阶段。

吉林农业大学菌物学教授王琦介绍,其中营养阶段叫作原生质团,黏菌原生质团主要生长在阴暗潮湿的环境,它会不断分裂成树枝形状,通过移动寻找食物。当条件适宜时,黏菌会进入繁殖阶段。

截至目前,全世界共发现黏菌1000多种,黏菌物种个体形态多样,如头发状的发网菌、盘蛇状的蛇形半网菌、酒杯状的高杯菌,生活中常见的黏菌有灰团网菌、暗红团网菌、灯笼菌、粉瘤菌等等。黏菌具有杂食性,一般不会主动对人体产生危害,但仍需注意保持饲养环境清洁,避免在污染严重的环境下饲养。饲养黏菌时也应注意个人卫生,避免直接接触口鼻眼等部位,接触后应当洗手。

黏菌看似普通
却解决了人类花百年规划设计的
铁路网
黏菌可以从一个点开始向四周伸展,寻找食物。一旦找到了食物来源,那么那些没有找到食物的“触手”就会收缩消失。最后在黏菌的觅食网上,就只留下了那些有食物供给,并且能有效传递营养的线路和节点。

黏菌甚至可以在迷宫里找到走出迷宫的最短路径。

2010年,日本北海道大学的科学家 Atsushi Tero 和同事在《科学》(Science)期刊上发表了一项研究,他们成功地用地燕麦片替代城市,在培养皿里让黏菌绘制了东京铁路系统的线路图。

让人惊掉大牙的是,黏菌绘制出的东京铁路系统,和人类百年来勤勤恳恳地通过反复试错修建出来的铁路网几乎一摸一样。

上面是黏菌用短短几天时间和一些燕麦片设计的,下面是人类花了100年和大量金钱设计的。
从那时起,许多做交通运输网优化研究的科学家就开始应用黏菌来设计交通网。
用黏菌来帮人类规划空间设计有不少好处,比如速度快、成本低、操作方便。黏菌平均每小时向外生长1厘米。只需要几天,它们就可以解决人类要花几年甚至数十年才能通过实践,或者借助超级计算机才能找到的优化方案。

用黏菌设计的非洲铁路网
另外,吉林农业大学菌物学教授王琦还表示,“黏菌体内及代谢产物中含有多种活性成分,例如脂肪酸、氨基酸、生物碱、芳香族化合物以及萜类化合物等等,具有抑菌、抗肿瘤、抗细胞毒及抗氧化的作用。以多头绒泡菌为例,其分离出来的环磷脂酸(CPA)可以抑制癌细胞的入侵及转移,而聚苹果酸(PMLA)则对人乳腺癌细胞展现出靶向性和高效性。目前,已被成功应用于癌症治疗的药物传递系统和生物成像等方面的医学研究,具有巨大的临床应用潜力。年轻人饲养黏菌可以学习到有关生物多样性和生态系统的基础知识,也让更多人了解到黏菌的食用及药用价值。”
黏菌以其独特的
生长方式和奇异的形态
受到科学家和艺术家的青睐
科学家和艺术家们通过观察黏菌的生长过程,将自己的感悟与黏菌独特的形态和生长纹路融入画作之中,形成了一幅幅别具一格的黏菌绘画作品。
德国近代生物学家、艺术家恩斯特·海克尔在19世纪末出版的《自然界的艺术形态》中,就绘制了精美绝伦的黏菌插画图鉴。

日本微生物学者江本義数,在其编著的《日本产变形菌原色图谱》一书中也展示了大量的精美黏菌插画,将肉眼几乎不可见的一些黏菌形态,放大数百倍呈现在笔端。


还有一位艺术家也十分擅长用黏菌入“画”,只不过画布是一个个色彩缤纷的培养皿。俄罗斯艺术家Dasha Plesen是一位微生物爱好者。她从空气、周围的环境、个人用品、宠物、汽车、地铁、灰烬、教堂、身体皮肤、古董等物体表面收集孢子,将培养基作为画布和孢子的食物,等待孢子的自然生长。这些黏菌孢子和霉菌、细菌等微生物,在生长过程中便产生了自然的色彩搭配。

如果真的想要饲养黏菌
应提前了解关于黏菌的一些选养知识:
↓↓↓
最后
小编替一些好奇的朋友问了
黏菌能吃吗?
